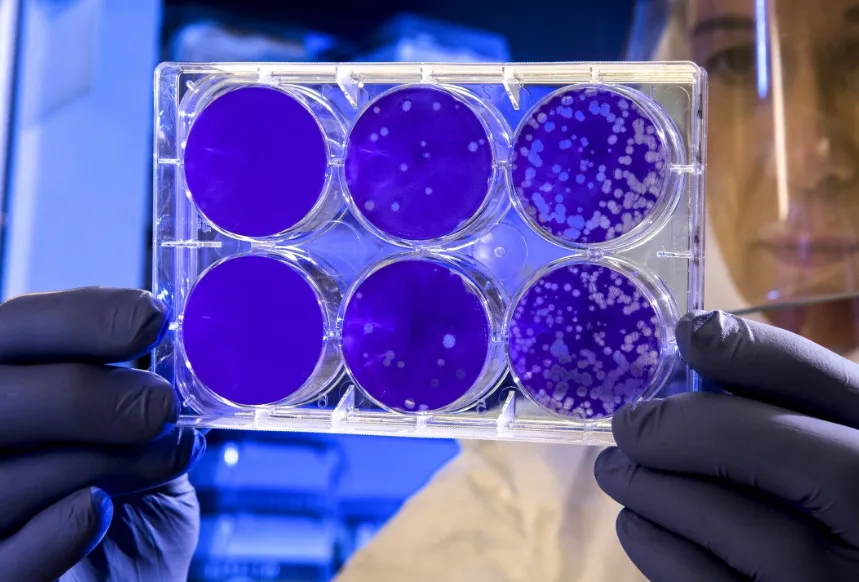
screenshot 20210819 143151

Het aantal coronagevallen in Duitsland neemt snel toe en de aan Nederland grenzende deelstaat Noordrijn-Westfalen gaat van oranje naar rood op de coronakaart van Europa. Dat geldt ook voor Berlijn, Hamburg, Sleeswijk-Holstein en Saarland. De rest van Duitsland gaat van groen naar oranje.
Vrijwel heel Duitsland met uitzondering van Hamburg stond twee weken geleden nog op groen, wat betekent dat de uitbraak er toen onder controle was. In eigen land gaat het alarmniveau deze week juist een stapje omlaag. Overijssel, Utrecht, Noord-Brabant en Gelderland gaan van rood naar oranje. Groningen, Friesland, Drenthe en Zeeland blijven op oranje staan. Noord-Holland, Zuid-Holland, Flevoland en Limburg staan ook de komende week nog op rood.
De laatste keer dat de kaart voor Nederland er zo gunstig uitzag was begin juli. Toen waren vier provincies groen en de rest van het land oranje. De week erna ging het hele land naar rood, en Groningen zelfs naar donkerrood, door het begin van de vierde golf.
Op de kaart van vandaag is heel Frankrijk roodgekleurd. Vorige week kleurde één regio nog oranje, maar ook daar neemt het aantal positieve tests toe. De situatie is het meest verontrustend aan de Middellandse Zee. In België ging Wallonië van oranje naar rood en ook in Oostenrijk neemt het aantal gevallen toe: vrijwel het hele land is nu oranje. Verder stijgt het aantal positieve tests in Scandinavië.
De situatie verbetert juist iets in Spanje. Regio’s als Catalonië, Valencia en Madrid zijn van donkerrood naar rood gezakt. In Italië is de situatie onveranderd, met regio’s als Toscane en Sardinië die op rood blijven staan. De coronakaart wordt elke donderdag gemaakt door het European Centre for Disease Prevention and Control, de Europese tegenhanger van het Rijksinstituut voor Volksgezondheid en Milieu.
De dienst kijkt naar het aantal vastgestelde besmettingen en het percentage positieve tests in de twee vorige kalenderweken. De uitbraak in Nederland stabiliseert zich: vorige week waren er bijna evenveel positieve tests als in de week ervoor, maar dat aantal is wel gedaald ten opzichte van de week daar weer voor. Als het aantal nieuwe gevallen gelijk blijft, verandert er volgende week waarschijnlijk weinig aan de coronakaart.